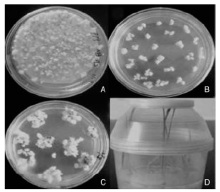

作者简介:沈春修(1979—),男,湖南溆浦人,讲师,博士,主要从事水稻抗逆性研究。E-mail:shenchunxiu@126.com
为探明 LOC_Os10 g05490位点冷胁迫条件下的表达特性和耐冷性功能,以耐冷东乡野生稻和冷敏感水稻93-11为试验材料进行了半定量分析,结果表明, LOC_Os10 g05490在冷敏感水稻93-11冷处理前后表达丰度相当,而在耐冷东乡野生稻中冷处理后表达丰度下调,这一结果与前期转录组测序(RNA-seq)结果相符,进一步验证了该位点可能与水稻耐冷相关,随后利用CRISPR/Cas9基因组编辑技术对 LOC_Os10 g05490编码区于同样具有较强耐冷性的粳稻品种台北309中实施定向基因敲除,并成功获得了26株转基因阳性植株。
To explore the expression and cold tolerance function of LOC_Os10 g05490 in rice under cold stress, semi-quantitative analysis was performed for Dongxiang wild rice and 93-11. The results showed that expression level of LOC_Os10 g05490 in 93-11 was the same before and after cold stress, but it was down regulated in Dongxiang wild rice after cold stress. This was consistent with RNA-seq data and further study indicated that this gene might be associated with cold tolerance in Dongxiang wild rice. Plant expression vectors with CRISPR/Cas9 genome editing technique were subsequently constructed to target the LOC_Os10 g05490 locus, and were transformed into the japonica rice variety TP309. A total of 26 transgenic positive plants were obtained. This study may lay the foundation for subsequent screening of mutant plants and identification of genes associated with cold tolerance in rice.
水稻是喜温作物, 低温冷害是影响水稻发育和生产的一种主要环境胁迫因子, 尤其对水稻苗期生长的影响和破坏最为严重, 挖掘水稻资源苗期耐冷基因、提高栽培水稻耐冷性对于稳定水稻产量具有重要意义。
从目前国内外的研究来看, 大多数学者认为水稻苗期的耐冷性表现是一个多基因控制的复杂性状。近十年来, 水稻苗期耐冷QTLs定位研究发展迅速, 已有许多关于水稻苗期耐冷相关QTLs成功定位的报道。钱前等[1]利用籼粳杂交获得的DH群体作为试验材料分别在水稻的第 1、2、3 和 4 染色体上检测到了与水稻苗期耐冷相关的 4个QTLs。陈大洲等[2]使用协青早B/东乡野生稻的 BC1F1群体, 在水稻的第4和第8染色体上发现了与东乡野生稻苗期耐冷性连锁遗传的SSR 标记 RM28和RM337。詹庆才等[3]利用二九青和Yukihlkari杂交, 然后再经过多代自交之后的重组自交系(RIL)群体为材料, 共定位了11个水稻苗期耐冷QTLs, 它们分别位于水稻染色体 1(2个)、2(2个)、3、5、6、7、8、9和12上。刘之熙等[4]利用籼粳交RIL群体, 以冷处理后的秧苗叶绿素含量、丙二醛含量及植株凋萎率为耐冷性指标, 在水稻的第9染色体RM105-RM257区间内定位到了一个主效QTL。郑加兴等[5]利用DP15和DP30为耐冷供体、9311为受体构建染色体片段代换系BC4F2, 以成苗率作为耐冷指标, 在水稻12条染色体上总共检测到19个与水稻苗期耐冷相关的QTL。夏瑞祥等[6]利用耐冷东乡野生稻和南京11构建的BC2F1分离群体为研究材料, 以根电导率作为耐冷性评价指标, 在水稻的第10染色体上SSR标记RM304-RM1108区间内检测到了2个主效QTL qRC10-1和qRC10-2, 它们对耐冷表型贡献率分别为34.13%和37.02%。目前, 利用这种连锁分析的方法在水稻的12条染色体上均已检测到与苗期耐冷性相关的QTL, 但连锁分析方法是利用系谱和标记信息, 将QTL定位在染色体上的一定区间范围内, 由于缺乏足够多的遗传重组事件, 基因定位过程中的置信区间一般较大, 无法鉴别目标性状的表达是单个基因还是多个基因共同作用的结果, 这也是目前水稻苗期耐冷相关QTL精细定位和克隆较少的原因之一。因此, 继续从耐冷性强的水稻材料中克隆耐冷相关基因很有必要。随着转录组测序技术, 尤其是RNA-seq(RNA sequence)技术的不断完善和测序成本的大幅下降, 以及一些新的分子生物学技术诸如CRISPR/Cas9(clustered regulatory interspersed short palindromic repeat/CRISPR associated proteins)基因敲除技术在基因功能研究中日益广泛的应用, 除定位克隆与同源基因克隆之外, 应重视胁迫条件下水稻耐冷相关基因的差异表达分析与敲除基因后的水稻突变体分析。
CRISPR/Cas9基因组编辑技术是继 ZFN(zinc finger nucleases)和TALEN(transcription activator-like effector nucleases)之后建立的又一新型靶向基因敲除技术, 该技术通过设计1个sgRNA-Cas9体系作用于研究对象, 导致目标靶位点的DNA双链发生断裂(DSB), 而后依赖生物体自身的同源重组(homologous recombination, HR)和非同源末端连接 (non-homologous end joining, NHEJ)对受损位点的修复作用而最终实现对基因组的改造[7, 8]。在生物的同源重组修复过程中, 当细胞内具有同源臂的靶DNA序列存在时, 携带有同源臂的外源基因就能够整合到靶标位点的DNA序列上。如将人工合成的供体 DNA 转入细胞, 那么生物体将以该DNA为模板, 可以有效地提高定点修饰基因的效率。相对同源重组修复而言, 非同源末端连接修复机制的保真性较弱, 非同源末端连接修复往往会导致DNA断裂处碱基发生突变, 通常情况下会造成碱基的缺失, 这种错误的修复方式如果发生在目标基因的外显子区域, 就会引起该基因编码阅读框发生改变, 使基因发生定点突变而导致基因功能的丧失[9, 10]。CRISPR/Cas9系统是一个由核酸和蛋白质组成的核糖核蛋白复合物, 该系统对靶标位点的识别是依赖于碱基的互补配对进行的, 靶向敲除一个位点只需要在原有载体的基础上替换20~30 bp的核苷酸, 相当于合成一对引物, 所以, 相对于ZFN和TALEN技术而言, CRISPR-Cas9靶向敲除技术的构建过程更加简单, 周期更短且效率更高, 适合于规模化、高通量的组装。目前, CRISPR-Cas9基因组编辑技术已被广泛应用于人体细胞[11, 12]、小鼠[13, 14, 15]、斑马鱼[16, 17]、酵母[18]、果蝇[19, 20]、线虫[21]、烟草[22]、拟南芥[23]及水稻[24]等作物的相关目的基因的功能研究中, 并取得了一定的成效。
基于前期耐冷东乡野生稻与冷敏感水稻93-11冷胁迫条件下(4 ℃处理3 d)的RNA-seq数据分析[25], 检测到LOC_Os10g05490位点冷处理后在耐冷东乡野生稻中的表达量显著下调, 而在冷敏感水稻93-11中冷处理前后无表达差异, 推测该基因可能与水稻的耐冷性相关, 本研究首先通过半定量分析验证了该基因在冷胁迫条件下的(4 ℃处理3 d)表达情况, 证实与表达谱测序结果一致后, 利用CRISPR/Cas9基因组编辑技术对LOC_Os10g05490编码区于同样具有较强耐冷性的粳稻品种台北309中实施定向基因敲除, 旨在获得该位点的敲除突变体植株, 从而为该位点的耐冷性功能鉴定研究奠定前期基础。
1.1.1 植物材料
耐冷水稻东乡野生稻、冷敏感籼稻93-11以及转基因受体材料的粳稻品种台北309, 均由本实验室保存并提供。
1.1.2 载体与菌株
CRISPR/Cas9克隆载体psgR-Cas9-Os是以pMD18 载体为骨架改造得到的(图1), 由中国科学院上海生命科学研究院惠赠, 植物双元表达载体pSK51(图2)、农杆菌菌株EHA105由本实验室保存, 大肠埃希菌感受态细胞Trans5α 购自全式金生物公司。
1.1.3 主要试剂
RNA 抽提试剂盒RNAiso Plus 及逆转录试剂盒PrimeScript Ⅱ 1st Strand cDNA Synthesis Kit购自宝生物技术有限公司; 限制性内切酶Bbs I、EcoR I和HindⅢ 购自Fermentas公司; GXL TaqDNA聚合酶购自TaKaRa公司; T4 DNA连接酶和质粒小量抽提试剂盒Easypure® Hipure Plasmid Miniprep Kit均购自全式金生物公司; 其他植物组织培养实验使用试剂均为国产分析纯产品。
1.2.1 半定量RT-PCR
将水稻幼苗于正常生长条件下培养至三叶期, 然后转移至4 ℃培养箱低温胁迫处理3 d 后取叶片组织于液氮中研磨成粉, 按试剂盒说明提取总RNA, 测定260、280 nm处的吸光值, 计算D260/D280比值, 确定总RNA的纯度。通过D260的值分别对处理前后的材料的总RNA进行定量。取等量处理前后不同材料的总RNA, 根据逆转录试剂盒说明合成第一链cDNA。根据水稻Actin基因序列设计特异性扩增引物:Actin-F: GACATTCAGCGTTCCAGCCATGTAT; Actin-R: TGGAGCTTCCATGCCGATGAGAGA; 扩增反应程序为:95 ℃ 5 min 预变性; 95 ℃ 30 s, 58 ℃ 45 s, 72 ℃ 1 min, 进行30个循环; 72 ℃延伸10 min。参考公共数据库中日本晴品种对应位点序列设计LOC_Os10g05490特异扩增引物:05490-F: TTCCAGCTTCTCTCAGACGC; 05490-R: GAACAGTAGGCTCGCCATG。 扩增程序:95 ℃ 5 min 预变性; 95 ℃ 30 s, 63 ℃ 45 s, 72 ℃ 1 min, 进行30个循环; 72 ℃延伸10 min。
1.2.2 目标基因靶位点选择、靶点接头分子设计和复性
在目标基因的外显子区域找到任意NGG(PAM)的位置, 选择其上游的20个碱基为靶位点序列(不含EcoR Ⅰ 和Hind Ⅲ 酶切位点), 根据靶位点序列合成2条携带接头的寡聚靶点接头分子Oligo1和Oligo2(Oligo1:5’ -TGGCACGGCGCCAGCATCACCGAC-3’ ; Oligo2:5’ -AAACGTCGGTGATGCTGGCGCCGT-3’ ), 接头序列与经Bbs I酶切后的载体粘性末端互补。将合成好的2条寡聚靶点接头分子用TE溶解成100 μ mol· L-1母液, 各取1 μ L加入到98 μ L 0.5× TE混合稀释到1 μ mol· L-1。约90 ℃ 30 s, 移至室温冷却完成退火复性(图3)。
1.2.3 靶点接头的克隆
将经退火复性制备好的双链靶点接头与经BbsⅠ 酶切后回收的Cas9克隆载体psgR-Cas9-Os按靶点接头与载体摩尔比约 3:1~5 :1的比例进行连接, 连接程序为22 ℃ 3 h, 16 ℃过夜连接[26]。而后将连接产物热激转化大肠埃希菌Trans5α , 选择PCR扩增产物电泳鉴定片段大小正确的阳性克隆菌株送上海铂尚生物技术有限公司测序, 测序结果正确的阳性克隆即为靶点接头的重组Cas9敲除克隆载体菌株。
1.2.4 测序及序列分析
所有克隆样品的测序均由上海铂尚生物技术有限公司完成, 测序数据在NCBI数据库中通过Align Sequences Nucleotide BLAST进行序列比对。
1.2.5 Cas9敲除植物表达载体转化水稻受体品种
使用电穿孔法将Cas9敲除植物表达载体导入根癌农杆菌EHA105感受态细胞中, 再借助农杆菌介导法[27, 28, 29]转化水稻受体品种台北309, 组织培养各阶段培养基参照李丁[30]使用的配方进行配制。
1.2.6 转基因植株PCR阳性检测
使用CTAB法分别提取T0代转基因水稻总DNA, 参考位于表达载体上的潮霉素抗性标记基因序列设计特异引物(Hpt-F:5'-GCTTCTGCGGGCGATTTGTG-3'; Hpt-R:5'-CTGAACTCACCGCGACGTCTG-3')对T0代转基因植株进行PCR阳性鉴定。扩增反应程序为: 95 ℃ 5 min预变性; 95 ℃ 30 s, 60 ℃ 30 s, 72 ℃ 1 min, 进行30个循环; 72 ℃延伸10 min。
通过对前期耐冷东乡野生稻与冷敏感水稻93-11在冷胁迫条件下(4 ℃处理3 d)的转录组数据进行比较分析[25], 检测到冷处理后在耐冷东乡野生稻中LOC_Os10g05490位点的表达量显著下调, 处理后该基因的表达量还不到处理前的1/32, 而在冷敏感水稻93-11中冷处理前后该基因表达量无差异(|log2Ratio|≥ 1符合差异表达)(表1), 为了验证这一结果, 本研究分别提取正常生长条件和冷胁迫条件下(4 ℃处理3 d)93-11和东乡野生稻幼苗叶片总RNA进行反转录, 以水稻肌动蛋白基因Actin的表达作为内标, 利用半定量RT-PCR方法对LOC_Os10g05490在冷处理前后的表达进行了比较分析, 结果表明, 半定量分析与转录组测序结果一致(图4), LOC_Os10g05490在冷敏感水稻93-11冷处理前后表达丰度相当, 而在耐冷东乡野生稻中冷处理后表达丰度下调。
| 表1 冷处理前后LOC_Os10g05490在93-11和东乡野生稻中的表达情况 Table 1 Expression of LOC_Os10g05490 in Dongxiang wild rice and 93-11 before and after cold treatments |
在LOC_Os10g05490的第一外显子区域设计靶位点接头引物, 将制备好的LOC_Os10g05490的双链靶点接头分别与经BbsⅠ 酶切后回收的Cas9克隆载体psgR-Cas9-Os进行连接, 并转化大肠埃希菌Trans5α 感受态细胞, 在含100 mg· L-1的氨苄青霉素的LB平板上过夜培养, 挑取单菌落摇菌后抽提质粒, 由于靶点接头太短不适合使用酶切鉴定, 本研究使用M13-F(位于载体上sgRNA的上游)和靶点接头引物(Oligo2)对阳性克隆进行了菌落PCR鉴定, 结果显示, 所有阳性克隆都扩增出了253 bp的目的条带, 只有以psgR-Cas9-Os空载体为模板的阴性对照未扩增出目的条带, 表明该基因靶标位点的Cas9克隆载体Cas9-05490已经构建成功(图5), 质粒送样测序结果也证实该基因靶标位点的Cas9克隆载体构建正确。
按图6所示方法进行LOC_Os10g05490靶标位点的Cas9敲除植物表达载体的构建, 将测序正确的LOC_Os10g05490重组Cas9克隆质粒Cas9-05490使用EcoR Ⅰ 和Hind Ⅲ 进行双酶切, 回收包含Cas9和引导RNA的约5.6 kb载体大片段, 然后与经EcoR Ⅰ 和Hind Ⅲ 双酶切后回收的约11 kb植物双元表达载体pSK51的大片段进行连接, 并转化大肠埃希菌Trans5α 感受态细胞, 在含50 mg· L-1的卡那霉素的LB平板上培养过夜, 挑取单菌落摇菌后抽提质粒, 使用EcoR I和Hind Ⅲ 进行酶切验证, 酶切鉴定结果表明, 该基因的Cas9敲除植物表达载体pSK51-Cas9-05490已经构建成功(图7), 重组质粒测序也证实了这一结果。
将经过酶切鉴定以及测序正确的重组质粒pSK51-Cas9-05490, 利用电激法转化到农杆菌菌株EHA105的感受态细胞中, 获得pSK51-Cas9-05490的农杆菌转化子后侵染受体水稻品种TP309的胚性愈伤组织, 经过共培养后, 将愈伤组织接入筛选培养基(含50 mg· L-1潮霉素)上, 适当延长筛选培养时间(3~4次筛选, 平均半月更换一次培养基), 获得抗性愈伤组织后, 经分化培养和生根培养等实验过程后, LOC_Os10g05490的Cas9敲除植物表达载体共获得34棵转基因植株(图8)。其中阳性植株26株, 阳性率达76.5%, 图9显示为部分转基因植株潮霉素抗性标记基因特异引物(Hpt-F和Hpt-R)PCR阳性鉴定结果。
在本试验中, 结合耐冷东乡野生稻与冷敏感水稻93-11在冷胁迫条件下(4 ℃处理3 d)的转录组测序比较分析[25]和半定量表达分析, 证实了水稻LOC_Os10g05490位点冷处理后在耐冷东乡野生稻中的表达量下调, 而在冷敏感水稻93-11中冷处理前后无表达差异, 推测LOC_Os10g05490位点可能在耐冷水稻的耐冷调控网络中发挥作用, 已经有报道在东乡野生稻的第10染色体上SSR标记RM304-RM1108区间内(Chr10:18211874-18716363)检测到了2个耐冷相关的QTL位点qRC10-1和qRC10-2[6], 而本研究通过在Rice Genome Annotation project网站(http://rice.plantbiology.msu.edu)中浏览查询该区间的所有基因位点, 发现LOC_Os10g05490位点并不位于这2个QTL位点所在区域, 表明该位点可能是一个新的水稻苗期耐冷相关基因位点。对于胁迫条件下转录组测序中与胁迫相关的上调差异表达基因, 一般可通过构建该基因的过表达载体和基因沉默(RNAi)来进行功能验证, 而本研究证实, 冷胁迫条件下LOC_Os10g05490位点在耐冷东乡野生稻中表达量下调。本研究利用CRISPR/Cas9基因组编辑技术对LOC_Os10g05490编码区于同样具有较强耐冷性的粳稻品种台北309中实施定向基因敲除, 后续通过分析该位点的敲除突变体植株在相同冷胁迫条件下的表现来鉴定该位点的耐冷性功能。
根据Rice Genome Annotation project网站(http://rice.plantbiology.msu.edu)中查询的序列信息和蛋白功能注释, LOC_Os10g05490基因全长2 811 bp, 共2个外显子, cDNA全长1 548 bp, 编码一种细胞色素P450单加氧酶类化合物, 单加氧酶(monooxygenase)广泛存在于动物、植物以及微生物体内, 主要参与生物体的内源性化合物的合成、降解以及外源性化合物的降解与活化等作用[31]。
李慧等[32]研究发现, 使用一定浓度的氯化钠、聚乙二醇、甘露醇或脱落酸处理杜梨幼苗时, 其中的甜菜碱合成相关的胆碱单加氧酶基因PbCMO在杜梨幼苗的根和叶中的表达量明显上调, 表明PbCMO对盐碱、干旱、渗透胁迫和ABA均存在胁迫表达响应, 该基因可能在杜梨应对非生物胁迫时参与相关转录调节。尹录录[33]通过对青蒿试管苗进行低温处理, 并采用半定量RT-PCR测定了细胞色素P450单加氧酶基因CYP71AV1的表达水平, 结果表明, CYP71AV1基因的表达受到冷胁迫的强烈诱导, 同时还发现CYP71AV1基因在冷胁迫条件下的诱导表达受到Ca2+通道抑制剂和Ca2+螯合剂的阻遏, 由此推测CYP71AV1基因的低温诱导表达可能受到Ca2+-钙调蛋白(CaM)信号转导通路的调控。潘丽娟等[34]通过半定量分析发现, 水稻幼苗组织中胆碱单加氧酶基因 OsCMO的表达受到高盐、低温以及干旱等胁迫的上调诱导, 表明该基因可能在水稻抵御非生物胁迫的过程中发挥作用。本研究发现, 在冷胁迫条件下水稻LOC_Os10g05490位点在耐冷东乡野生稻中的表达量显著下调, 而在冷敏感水稻93-11中冷处理前后无表达差异, 这与以往研究者报道的单加氧酶基因在非生物胁迫条件下表达量出现上调的结果不一致, 说明在不同植物中或者相同物种的不同品种之间, 单加氧酶基因在非生物胁迫响应过程中可能存在不同的转录调节机制。因此, 单加氧酶基因在植物响应非生物胁迫中的作用及分子机制还有待进一步深入研究。
The authors have declared that no competing interests exist.
| [1] |
|
| [2] |
|
| [3] |
|
| [4] |
|
| [5] |
|
| [6] |
|
| [7] |
|
| [8] |
|
| [9] |
|
| [10] |
|
| [11] |
|
| [12] |
|
| [13] |
|
| [14] |
|
| [15] |
|
| [16] |
|
| [17] |
|
| [18] |
|
| [19] |
|
| [20] |
|
| [21] |
|
| [22] |
|
| [23] |
|
| [24] |
|
| [25] |
|
| [26] |
|
| [27] |
|
| [28] |
|
| [29] |
|
| [30] |
|
| [31] |
|
| [32] |
|
| [33] |
|
| [34] |
|